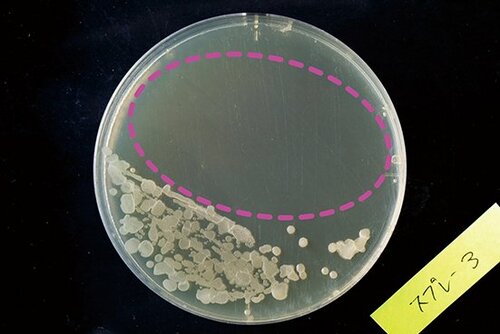
【S評価】カビ菌の増殖をしっかり防ぐ！ アース製薬防カビスプレー イメージ
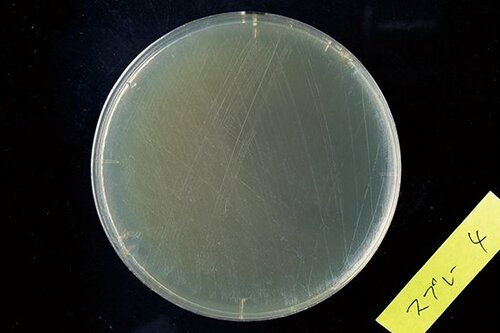
【A評価】コスパと握りにくさで惜しい結果に…レックのカビ予防 イメージ
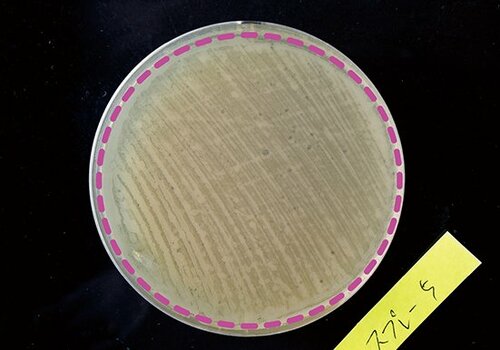
C評価: 【C評価】菌がついてしまった…リベルタカビダッシュ イメージ
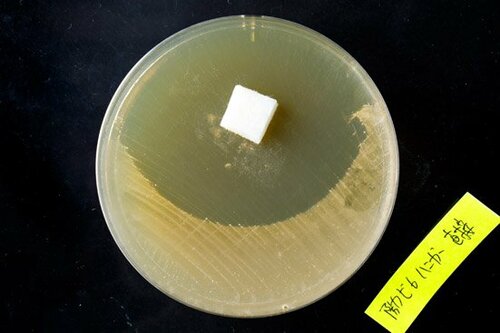
【ハンガータイプ】付けるだけ！おふろの防カビアロマ イメージ

カビ掃除は、もう古い!“生えなく”させるのが最新です
お風呂の床や壁・天井など、いつの間にかあちこちに生えているカビを掃除するのは、かなりストレスですよね。しかも、うっかり掃除をさぼっちゃうと、しつこく根を張ってしまうことも……。

ここまでカビが生えるとお手上げ……。
でも、だったらカビを生えなくすればいいんです! じつは、最強の防カビグッズを使えば、カビを発生から防ぐことができます。今回は、そんな防カビをうたう3製品の中から、オススメの逸品をご紹介します。
【S評価】カビ菌の増殖をしっかり防ぐ! アース製薬防カビスプレー
カビ菌の増殖をしっかり防ぎつつ、コスパも良かったのがアース製薬のらくハピ。フローラルの香りなので、不快感なく使用できるところもうれしいポイントでした。

アース製薬
らくハピ 水まわりの防カビスプレー
ピンクヌメリ予防(400ml)
実勢価格:475円
防カビ力:◎
コスパ:◎
[カビの増殖テスト]
菌を培地につけて、スプレーしてみました。スプレーが当たっている点線内は、カビ菌の増殖がしっかりおさえられましたが、当たっていない部分は菌が発生しています。

スプレータイプなので、床や壁にシュッとひと吹きするだけ。コスパも考えると、アース製薬が堂々のトップとなりました!
【A評価】コスパと握りにくさで惜しい結果に…レックのカビ予防
レックの防カビ剤も十分に効果がありましたが、アース製薬と比べると、若干お値段高め。また、スプレーの握り具合がイマイチでした。

レック
浴室用カビ予防(320ml)
実勢価格:593円
防カビ力:◎
コスパ:○
[カビの増殖テスト]
菌の増殖はほとんど見られません!
C評価: 【C評価】菌がついてしまった…
リベルタカビダッシュ
こちらは、噴射タイプのカビ予防剤です。アース製薬、レックと同条件のテストを行いましたが、しっかりと菌がついてしまいました。この価格なら、迷わずアース製薬をオススメします。

リベルタ
カビダッシュ
お風呂まるごと防カビ・抗菌
スパークリングジェット
実勢価格:1890円
防カビ力:△
コスパ:△
[カビの増殖テスト]
全面に菌が増殖してしまいました。
その他、燻煙タイプとハンガータイプもテストしてみましたので、ご紹介します。
【薫煙タイプ】菌の増殖はなしアース製薬お風呂の防カビ剤
こちらは、アース製薬の薫煙タイプの防カビ剤です。スプレータイプと同じように菌を培地につけて使用したところ、菌は増殖しませんでした。
ちょっと手間がかかりますが、効果はバッチリ。

アース製薬
らくハピお風呂の防カビ剤
フレッシュフローラルの香り
実勢価格:476円
※Amazonあわせ買い対象商品です

菌の増殖は抑えられています。
【ハンガータイプ】付けるだけ!おふろの防カビアロマ
浴室の天井や壁に取り付ければ、約90日間カビ対策ができるというアイテムです。塩素系成分は使用されていないので、安心して使えます。

(画像をクリックすると購入ページへ移動します)
トキワ産業
おふろの防カビアロマ消臭プラス
ピュアラベンダーの香り 17mkl
実勢価格:861円
中に入っていたろ紙を取り出し、培地にセットして検証。ろ紙のまわりには菌が増殖しませんでした。
以上、カビを生えなくさせる防カビ剤をご紹介しました
これを使って、もうカビ掃除とはさよならしましょう!



